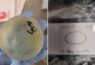

[ad_1] Steven McIntoshEntertainment reporterGetty ImagesThe closing credits of 2021's No Time To Die, the most recent film in the 007 series, ended with a familiar message: "James Bond will return."But for the last few years,…
BJP will be wiped out from U.P. in…
[ad_1] Samajwadi Party National President Akhilesh Yadav is being garlanded by party workers and engineers during a press conference on the occasion of Engineers’ Day at the party office, in Lucknow on Monday, September 15,…
Holiday park wiped out by Texas floods
[ad_1] A major search and rescue operation is under way in Texas after flash floods killed at least 24 people.The Guadalupe River rose 26 feet (7.9m) in less than an hour and the deluge that…
Hackers say they wiped out USD 90 million…
[ad_1] Dubai, Jun 19 (AP) Hackers with possible links to Israel have drained more than USD 90 million from Nobitex, Iran's largest cryptocurrency exchange, according to blockchain analytics firms. The group that claimed responsibility for…
Chinese student held for smuggling ‘biomaterial’; wiped device…
[ad_1] A Chinese national has been arrested at Detroit Metropolitan Airport for allegedly smuggling biological material into the United States, marking the second such incident in recent days. Chengxuan Han, a Ph.D. student at Huazhong…
Caught in Trump-Musk crossfire: Tesla stock sinks amid…
[ad_1] The unlikely political marriage between US President Donald Trump and Tech Billionaire Elon Musk has ended in a fiery public divorce with Tesla's shares paying the price. The fallout began after Musk openly slammed…
$100 billion wiped out! Tesla shares crash 17%;…
[ad_1] Tesla shares have crashed 17% after CEO Elon Musk and US President Donald Trump's spat turned ugly on Thursday. Musk, known to be one of Trump's biggest supporters has been critical of the US…
Swiss glacier collapse: How the village of Blatten…
[ad_1] “I was speechless,” said Matthias Huss, a leading glacier specialist at Zurich’s Federal Institute of Technology. “It was the worst case that could happen.” Mr Huss had been aware of the situation in Blatten;…
Millions to be wiped out financially: Rich Dad…
[ad_1] Sounding the alarm bell following weak auction results for a $16 billion sale of 20-year bonds, best-selling author Robert Kiyosaki predicted: THE END is HERE.Taking to the social media platform X, the Rich Dad…